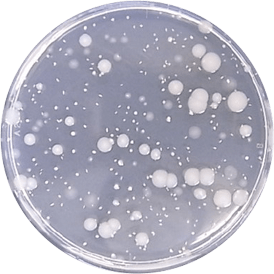
抗菌処理なし

ショールーム
SHOWROOM会社情報
COMPANY INFORMATIONお客様窓口
SUPPORTプロユーザーサイト
for Professionalパース制作やプレゼンテーションに使える商品の素材画像、CADデータ、
提案書等のダウンロード、カタログ・サンプル請求など各種サービスをご利用いただけます。
データダウンロード
パース制作やプレゼンテーションに使える各種データ・資料をダウンロードいただけます。
カタログ・サンプル請求
弊社商品やサービスに関するカタログおよびサンプルをご用意しております。


SCROLL
特徴1. 傷と水に強い
天然木である以上、硬いものを落とすと傷がつく可能性はありますが、「WOODRIUM FOR KITCHEN」には、そうした傷から水分が浸透して起こる不具合を防ぐ工夫が施されています。
表面の挽き板には、5層にわたるウレタン塗装を施すことで、塗膜の強度と耐久性を高めています。中塗りには柔軟性のある塗料を採用しており、凹み傷に追従する形で塗装のひび割れを抑える構造です。
さらに、表面の挽き板には十分な厚みがあるため、万が一深い傷がついても芯材が露出する心配はありません。
-
ワークトップ断面図
表面塗装構造
-
水染み試験
鋼球落下試験の凹み箇所を含めるように円筒を立て、水が漏れないようコーキングをする。円筒に水を満たして、表面状態の変化を観察する。
一般的な塗装品
(タモ集成カウンター)塗膜ワレから徐々に水が浸透し、水シミがどんどん濃くなっていく。
WOODRIUM FOR KITCHEN
塗装品(ワークトップ)90日経過で水染みなし
-
塗装回数
特徴2. 抗ウイルス・抗菌仕様で安心
「WOODRIUM FOR KITCHEN」の塗膜は、SIAA(抗菌製品技術協議会)認証の抗ウイルス・抗菌性能をはじめ、
5つの衛生性能を備えた、安全性と清潔性に優れた仕様です。
5つの衛生性能を備えた、安全性と清潔性に優れた仕様です。
-
【抗ウイルス性能】

-
【抗菌性能試験結果】

大腸菌
ヒトの腸管の常在菌。いくつかの種類があり、病原性を持つものを病原性大腸菌と呼ぶ。中でもO-157はベロ毒素を産生し、特に毒性が高く、感染すると下痢、血便を生じ、場合によっては重症化する。

抗菌処理なし
抗菌処理あり初期値 1.8×10⁵ / 試験片 1.8×10⁵ / 試験片 24時間後 4.0×10⁵ / 試験片 10未満 / 試験片 黄色ブドウ球菌
ヒトの皮膚や鼻腔の常在菌で、ブドウの房状に発育する。「毒素のデパート」と呼ばれ、種々の病原性を持ち様々な感染症を引き起こす。このうち、抗生物質メチシリンの耐性を持ったMRSAは、院内感染の主要な原因菌の1つ。

抗菌処理なし
抗菌処理あり初期値 2.1×10⁵ / 試験片 2.1×10⁵ / 試験片 24時間後 1.2×10⁵ / 試験片 10未満 / 試験片 ※製品表面に細菌の入った液を滴下し、35℃、90%以上の環境で24時間培養した後に洗浄。その洗浄液を培養液に入れ、35℃で48時間培養し、菌数を測定する。
※試験データの数値は試験値であり、保証値ではありません。
特徴3. お手入れしやすい
キッチンで想定される調味料や油分などの汚れに対して、さまざまなケースを想定した検証を実施しています。
飲料や調味料、アルコールなどをうっかりこぼしてしまっても、水拭きで簡単に汚れを取り除けます。
また、キッチン用の塩素系除菌漂白剤(次亜塩素酸ナトリウム)やアルコールを使用しても、塗装面を傷めることなく、衛生的にお使いいただけます。
飲料や調味料、アルコールなどをうっかりこぼしてしまっても、水拭きで簡単に汚れを取り除けます。
また、キッチン用の塩素系除菌漂白剤(次亜塩素酸ナトリウム)やアルコールを使用しても、塗装面を傷めることなく、衛生的にお使いいただけます。
-
【耐汚染性能】
雑菌繁殖のもととなる汚れをきれいに拭き取れます。
ファミリープルーフ試験
家庭で使用する10種類の材料(醤油・ソース・コーヒー・マヨネーズ・ケチャップ・酢・緑茶・ウイスキー・油・赤ワイン)を製品表面に滴下し、6時間放置後拭き取り。さらに24時間乾燥させた表面を評価。 -
汚染A試験
黒マジック・赤クレヨン・青インクで製品に線を引き、4時間放置後溶剤で拭き取った表面を評価。 -
【耐薬品性能】
キッチン用の塩素系除菌漂白剤(次亜塩素酸ナトリウム)やアルコールをご使用いただけます。
※この商品は特定のキッチンメーカー様向けの製品のため、
一般の流通ではお求めいただけません。
一般の流通ではお求めいただけません。

![[対談] WOODRIUMがインテリアデザインを拡張する](https://corp-prod-01.woodtec.co.jp/cms/wp-content/themes/woodtec/assets/images/woodrium/bnr_dialogue.jpg)











